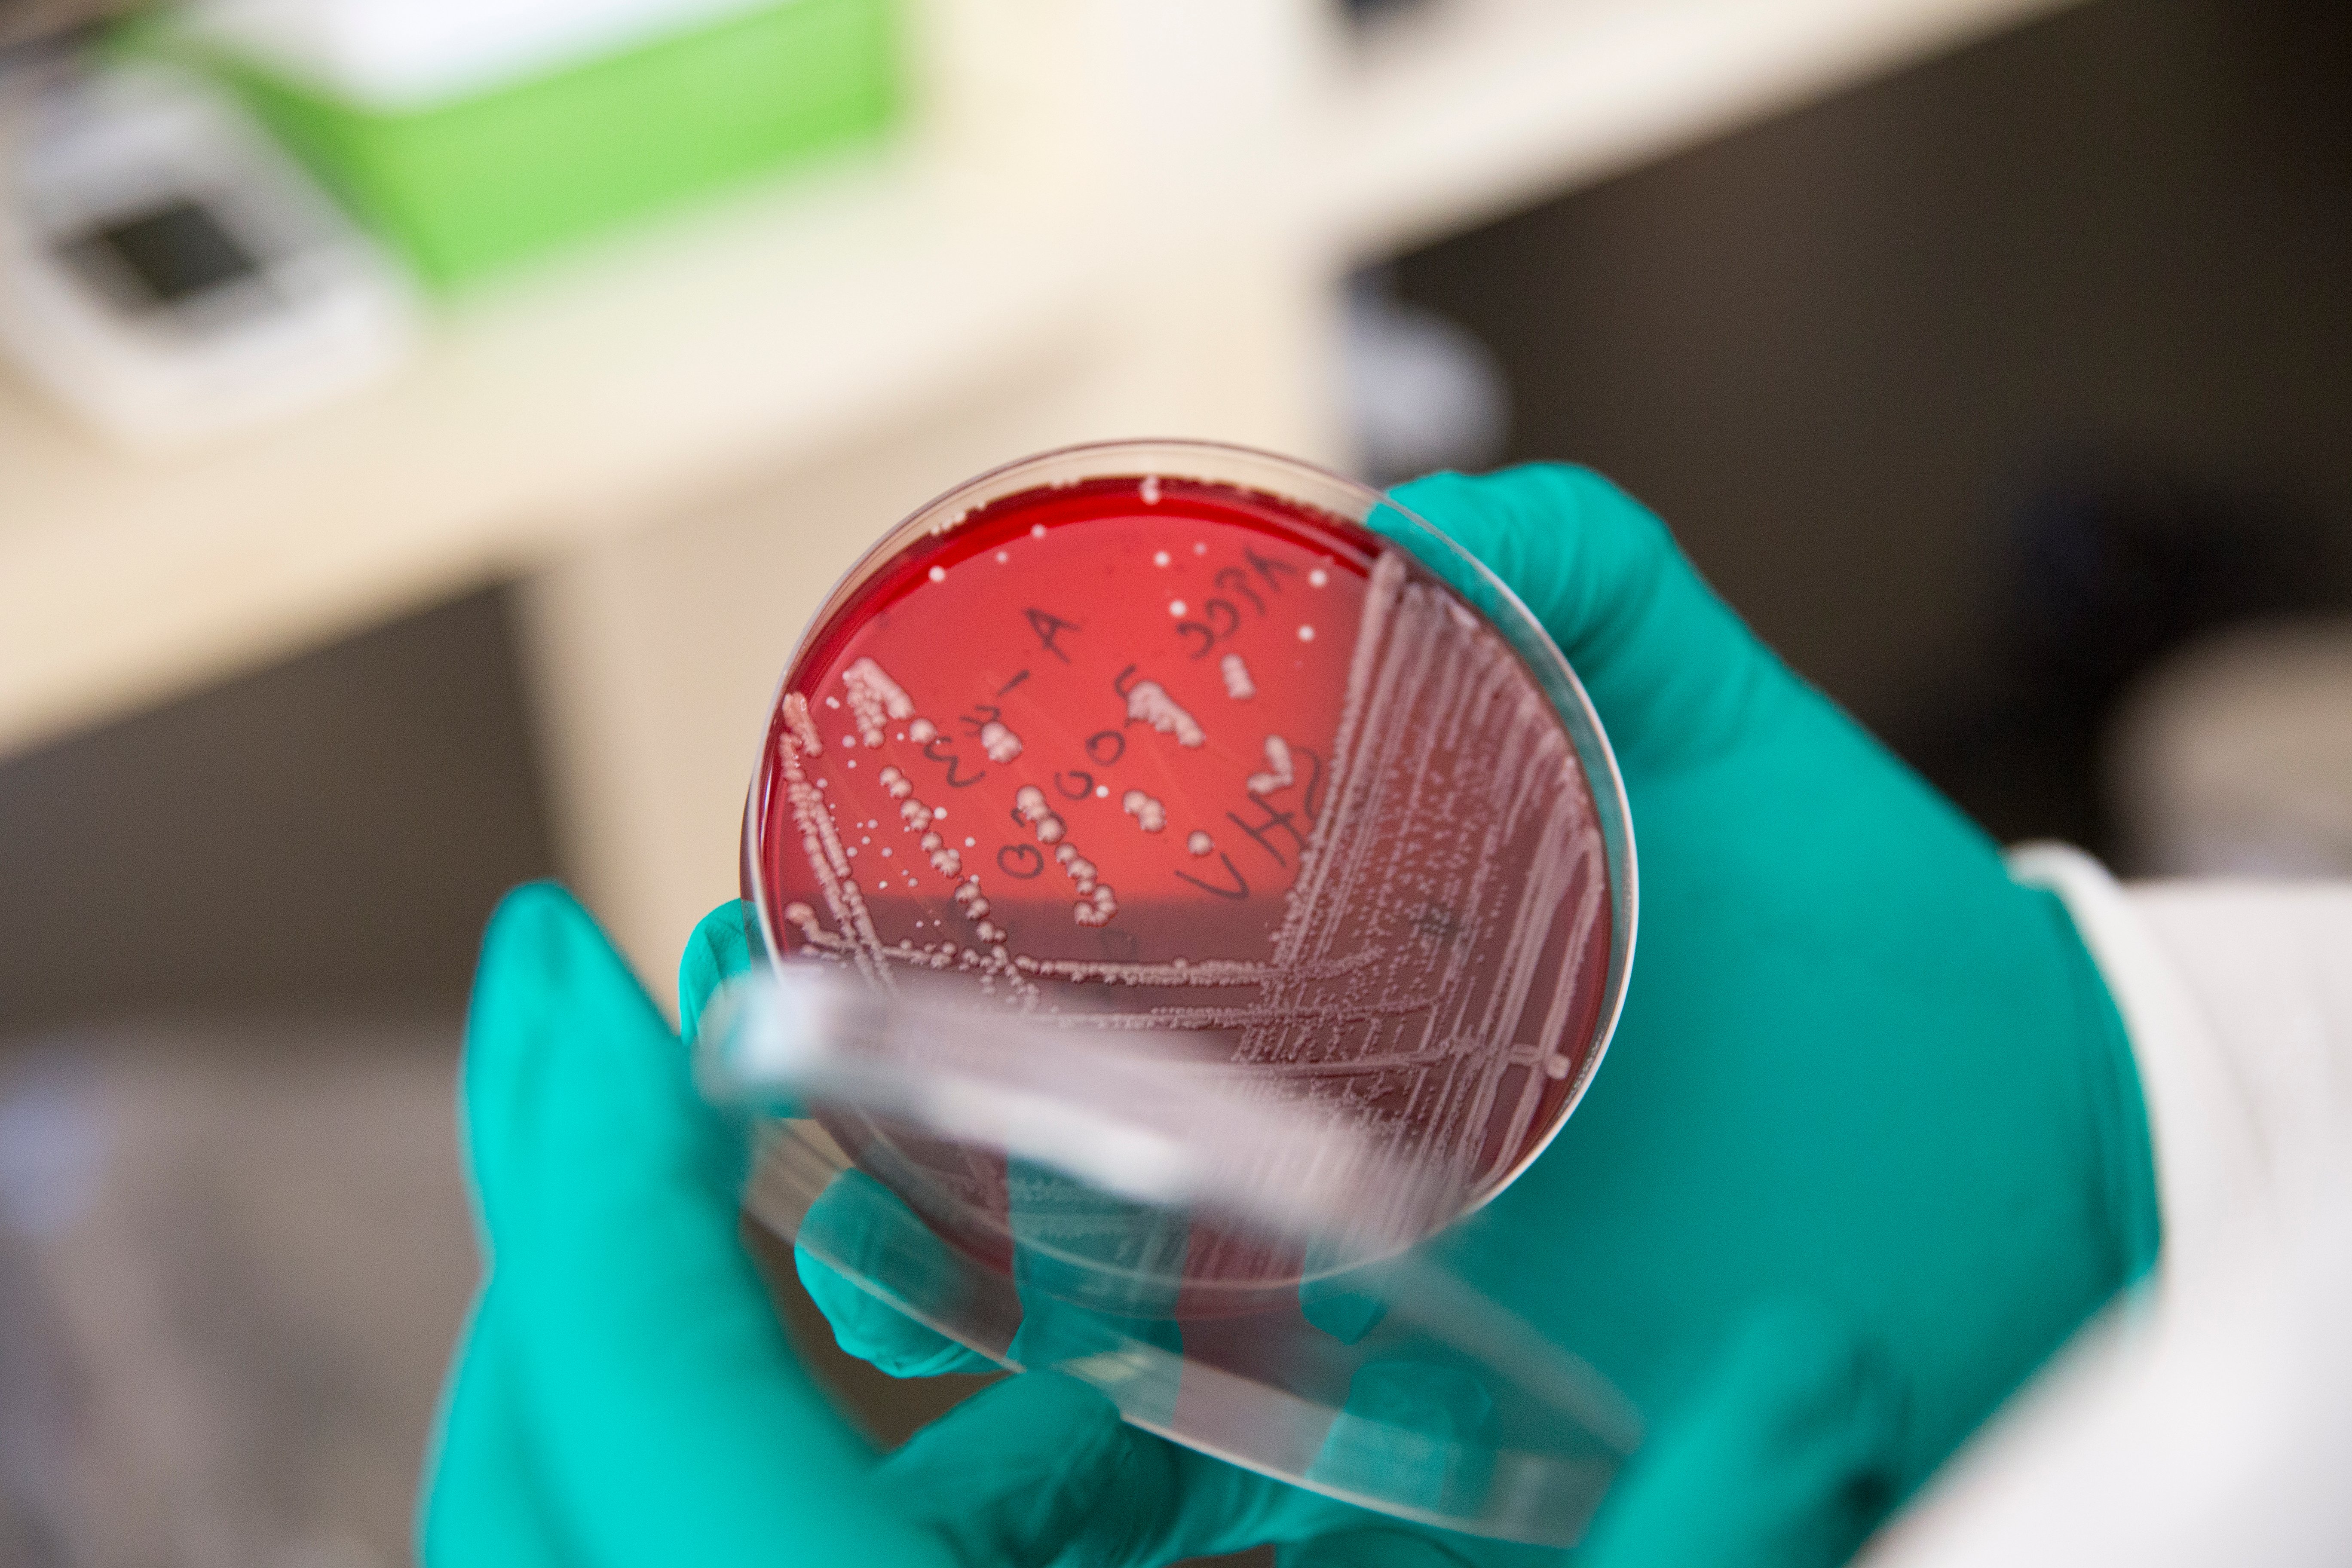
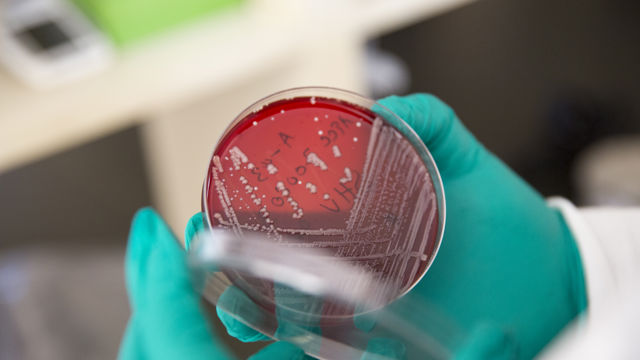

Combating infectious diseases
Infectious diseases such as malaria, tuberculosis and hepatitis are much more widespread in developing countries than in rich countries. Many cases of illness and death could have been prevented or treated with simple means. One of Norway’s main priorities within global health is combating infectious disease.
What
Since the turn of the millennium, there has been a significant decline in the mortality rate of infectious diseases such as malaria, tuberculosis, polio and HIV, but there is still a long way to go before we can see the end of these epidemics. Major outbreaks of other infectious diseases such as COVID-19, Mpox, Cholera and Ebola also show that continued efforts are necessary to keep infectious diseases under control.
An increasing proportion of the population in developing countries are also affected by non-communicable diseases such as cardiovascular disease, diabetes and cancer. This results in a double disease burden in many low- and middle-income countries.
Achieved results and further progress are challenged by e.g. war and conflict, migration, that gender equality and human rights are under pressure in many countries, shrinking civic space, drug resistance and climate change.
Efforts to strengthen national health systems are key to ensure a sustainable response, as well as to prevent, prepare and respond to new pandemics.
Why
The burden of disease in the poorest countries is still characterized by infectious diseases that are preventable and treatable, such as HIV, hepatitis, tuberculosis and malaria. In addition to diarrhoea and respiratory diseases such as measles in children, account for the greatest health challenges in developing countries. This is especially true in southern Africa. Combating infectious diseases is therefore a priority in Norway's development policy
Link: Burden of Disease – Our World in Data
How
The efforts to combat infectious diseases primarily take place through multilateral organisations and funds.
Through political leadership, technical cooperation and funding for Norwegian and international organisations and individual countries, Norway contributes to the work to prevent new cases of disease and improve access to vaccines, effective diagnostics and treatment.
Through these organisations, Norway helps stimulate and accelerate the development of vaccines against both new and old infectious diseases, ensure that drugs for prevention, diagnosis and treatment are available at an affordable price, fund national efforts, support civil society’s work, etc.
In the post COVID-19 pandemic period, regional production has become an important measure in ensuring fair access to life-saving drugs. Norway supports this work both financially and through technical collaboration with main partners in this area.
Our key agreement partners can in a simplified way be classified as follows:
Financing national programs. Research & development
The Global Fund The Global Fund to Fight AIDS, Tuberculosis and Malaria
Gavi Gavi, The Vaccine Alliance
Unitaid Home - Unitaid
CEPI Home page | CEPI
Normative and technical:
UNAIDS UNAIDS
WHO World Health Organization (WHO)
Civil society, service delivery and advocacy:
Robert Carr Fund Robert Carr Fund
LHLI LHL International
Who/Where
Norway’s partners undertake work in more than 100 countries, with a primary emphasis on southern Africa.
Depending on the disease, some people are more vulnerable than others. Children under five years of age and pregnant women are at the greatest risk of malaria, while the poorest people are at the greatest risk of developing tuberculosis. People most at risk for HIV include young women in Africa, men who have sex with men, transgender people, people in prison, people who sell sex and people who use drugs.
To bring an end to several of these epidemics, including HIV, it is necessary to reduce stigma, discrimination and criminalisation of particularly vulnerable groups.
As gender equality and human rights related barriers often stand in the way for an effective response, gender equality, human rights and sexual and reproductive health and rights are prioritised in our efforts.
Contact
For more information, please contact the Department for Human Development